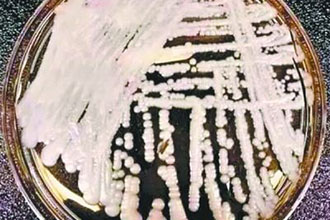
timg-(3).jpg

|
超级真菌?需要重视但无需恐慌中国数字科技馆 2019-05-07 |
4月上旬,《纽约时报》一篇关于致命真菌“耳念珠菌”的报道引发了媒体和大众的关注。综合相关媒体报道可知,这种真菌在10年内相继在不同国家现身,大部分菌株对临床使用的3大抗真菌药物均具有耐药性,致死率高达60%;美国感染者约有半数在90天内死亡,美国疾病控制和预防中心(CDC)将耳念珠菌列入“紧急威胁”名单,其监测数据显示截至今年2月美国总计上报617例患者。
在《纽约时报》的报道引发关注之后,“超级真菌”登上了我国微博热搜榜。“致死率高”“无有效治疗方法”“美国大范围爆发”“中国出现18例感染病例”……这些关于耳念珠菌的抓人眼球的只言片语迅速扩散,如果不细致查看相关报道,甚或看了一些不实谣言,普通百姓可能会担心超级真菌感染会不会大范围爆发,恐慌自己会不会感染。事实上,我们应该重视超级真菌,但这种担心和恐慌却是不必要的。让我们一起来看看专业医师怎么说。
“所谓的超级真菌俗称耳念珠菌,学名耳道假丝酵母菌(Candida auris)。它其实不是新近突然进化出来的物种,早在十年前,即2009年,就已经在日本被发现了,随后的十年间,不断在世界各地检测出来,包括我国。

培养皿中的耳念珠菌菌株。图/美国疾病控制和预防中心
它属于侵袭性真菌,可以侵入血液,感染心脏、脑等人体重要器官,导致严重感染,尤其会导致医院里或者老人护理机构里重症患者的死亡。
它常常对多种抗真菌药耐药,常用的抗真菌药有时对它不起作用。它很难被识别出来,有被误报为其他念珠菌种的可能。
它更容易在医院和老人护理机构等地方传播,引起医院内的爆发性流行,主要通过接触病人以及接触被病人污染过的物体表面传播,因此勤洗手和彻底清洁院内物品是阻断它传播的重要手段。
至于这种超级真菌是从哪里来的?它是怎么进化的?它为什么在最近几年越来越多?它为什么会对主流抗真菌药耐药等问题,医学界尚未研究清楚,科学家们仍然在努力研究中。
目前,对于耳念珠菌,我们不必恐慌:
耳念珠菌对健康人不会造成太大的影响。感染主要发生在医院内,集中在免疫力低下的人群,如重症监护病房。美国的大规模流行也都是在医院内发生的。而对于有正常免疫力的健康人群而言,发生这种感染的风险明显降低。
并不是所有耳念珠菌都是超级耐药的。即使是对于多重耐药真菌仍有希望通过提高抗真菌药物的剂量或联合用药达到清除真菌的效果。”(清华大学附属北京清华长庚医院,普内科主任医师马序竹)
怎么样,是不是安心了,超级真菌对健康人群根本不够成威胁。既然超级真菌耳念珠菌主要在医院内通过接触传播,感染者多是住院病人,那么对于一般人来说,去医院后及时用肥皂水洗手等保持清洁卫生,就能起到预防作用,无需采取特殊的防护措施,更不必恐慌。
其实,提到超级真菌,很多人会联想到超级细菌,因为超级细菌被报道、谈论地更多,影响更广泛。超级细菌,通俗地说就是具有很强的抗生素耐药性的细菌。我们常谈论的抗生素滥用问题,就与细菌耐药性的加快出现有关。

百度关于超级细菌的部分搜索结果
世界卫生组织指出,抗生素耐药性是对目前全球卫生、食品安全和发展的最大威胁之一,它会影响到每一个人,越来越多的细菌感染,例如肺炎、结核病、淋病等,变得更难治疗,原因就在于治疗感染的抗生素的有效性下降。为了防控抗生素耐药性的蔓延,我们平常能做的是生病时不要自己随意吃抗生素类药物,除非是专业医师开具的药物,例如头孢类药物、氟喹诺酮类药物(如诺氟沙星、氧氟沙星等),也不要主动向医生要求使用抗生素,不向他人分享自己剩余的抗生素药物。

事实上,除了细菌、真菌,致病微生物还有病毒、寄生虫等。我们在治疗这些微生物导致的疾病时,会使用各种各样的药物,这些药物可以统称为抗微生物药,像细菌、真菌在暴露于药物时会发生改变从而对原有药物出现耐药性一样,病毒、寄生虫等微生物也会出现耐药性,这些统称为抗微生物药物耐药性。抗微生物药物耐药性涵义更加广泛,因为抗微生物药涵盖了抗生素、抗真菌药、抗病毒药、抗疟疾药和驱虫药等。产生抗微生物药物耐药性的微生物就被冠以“超级”的名号,就像前面讲的超级细菌、超级真菌。
抗微生物药物耐药性问题是一个全球性的问题,影响着我们每一个人。举个简单的例子,试想一下,如果流感来袭,我们却没有抗病毒药物可以治疗,该怎么办?事实上,根据世界卫生组织的资料,几乎所有在人类中传播的甲流病毒都对M2抑制剂类抗病毒药物具有耐药性。好在,目前我们还有其他抗病毒药物(神经氨酸酶抑制剂奥司他韦)可用,如果以后某一天现有药物全部失效的话,可能只有科学家们研制出新的可用药物才能拯救我们了。
为了预防和控制抗微生物药物耐药性问题,我们普通人可以通过简单的方式出一份力:
治病时一定要遵医嘱,不随意用药;也不要给饲养的宠物、家禽等滥用抗微生物药物。
责任编辑:王超
 科普中国APP
科普中国APP
 科普中国微信
科普中国微信
 科普中国微博
科普中国微博

最新文章
-
为何太阳系所有行星都在同一平面上旋转?
新浪科技 2021-09-29
-
我国学者揭示早期宇宙星际间重元素起源之谜
中国科学报 2021-09-29
-
比“胖五”更能扛!我国新一代载人运载火箭要来了
科技日报 2021-09-29
-
5G演进已开始,6G研究正进行
光明日报 2021-09-28
-
“早期暗能量”或让宇宙年轻10亿岁
科技日报 2021-09-28
-
5G、大数据、人工智能,看看现代交通的创新元素
新华网 2021-09-28













